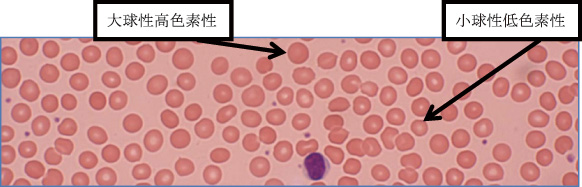

=== 新春随筆 ===
2020年東京オリンピック
|
|
東区・郡元支部
(デイジークリニック) 武元 良整
|
|
<21世紀はスポーツの時代>
オリンピックが2020年東京で開催されます。臨床の現場でも「アスリートの健康管理」の面から「疲労・体調不良を訴える症例」を診療する機会が増えて来ました。すでに,スポーツの現場ではKAGO食スポーツという会社(http://kg-sport.com)が管理栄養士/公認スポーツ栄養士の立場から「アスリート健診」を提案し2020年鹿児島国体へ向けて中学,高校生の健康管理,食事指導に取り組んでいます。国内事情として,団塊の世代がシニア層で急増するため,「スポーツ奨励」「カラダを動かす」という啓発は膨張を続ける医療費削減にむけての課題でもあります。同様の活動は海外でも注目されています。筋力がつけば生活習慣病などの医療費の削減になる(降圧効果,血糖安定,脂質異常症改善,転倒予防,緑内障改善など)という国際的な学術報告がみられます。日常的にシニアの世代へは「ラジオ体操」「貯筋運動:鹿屋体育大学推奨」「ポールウオーキング」など転倒予防にも有用な運動の提案・推奨がなされています。健康増進にはスポーツを介して「カラダを動かす」がキーワードとなっています。
<スポーツ選手の健康管理>
血清ハプトグロビン低値の意味
2年前,陸上部高校生が「疲労,たちくらみ,口内炎,練習中に意識消失」を主訴に来院。
この症例1のCBC:全血算(complete blood count)は以下の結果です。
| RBC:436万/μL,Hb:13.2g/dL,Ht:39.7%,MCV (mean corpuscular volume:平均赤血球容積):91.1f
L,MCH(mean corpuscular hemoglobin:平均赤血球血色素値):30.3pg,PLT(血小板数):27.5万/μL |
貧血診断の基準からは正常。スポーツ貧血(鉄欠乏状態and/or行軍血色素尿症)を疑い精査したところ,血清ハプトグロビン低値(溶血亢進を意味する)にて測定不可,行軍血色素尿症と診断しました。血色素(Hb)値が見かけ上は正常範囲(代償性貧血)のことが多く,診断は困難です。
この症例は行軍血色素尿症の診断のもと,3カ月間の治療後に陸上部の大会に出場し,良好な成績を収めています。さて,その治療内容は貧血症状高度のため,最初は鉄剤静注施行,その後は鉄剤とビタミンB12と葉酸の3剤内服併用としました。治療開始前の血液生化学の所見は以下です。
| 血清フェリチン:11.9ng/mL,(12.0以下は鉄欠乏:WHO基準)ビタミンB12:363pg/mL(基準値180-914pg/mL),葉酸:5.6ng/mL(基準値4.0ng/mL以上) |
Hb値が正常範囲で,血清フェリチンが12.0以下と「潜在性の鉄欠乏状態」です。
治療後5カ月の検査結果は以下です。ほとんどの項目で数値は改善しました。
RBC:450万/μL,Hb:14.2g/dL,Ht:42.1%,MCV:93.6f L,MCH:31.6pg,PLT:21.5万/μL
血清フェリチン:171.2ng/mL,ビタミンB12:949pg/mL,葉酸:195ng/mL |
この5カ月後の時点でも,血清ハプトグロビンは依然として低値,測定不可でした。
メモ
行軍血色素尿症:運動によって誘導される溶血性貧血。
繰り返しの運動で足の裏の血管内で赤血球が踏み潰されるというスポーツ独特の機序があり,オーバートレーニングを続けるとより重度となる。 |
|
図 1 症例1の初診時,末梢血液像は大小不同1+あり,多染性1+です。
(末梢血液画像は鹿児島市医師会臨床検査センター血液検査室へ依頼し撮影いただきました) |
<行軍血色素尿症の11例>
さて,スポーツ選手の健康管理で日本陸連(http://www.jaaf.or.jp/)が「過剰な鉄分は身体に害です!」「アスリートの貧血対策7カ条」を提唱しています。その中で「疲れやすい,動けないなどの症状は医師に相談」という項目があります。
部活で疲れやすいなどの貧血症状を主訴に来院した11例の中学・高校生の特徴を報告します。貧血症状の訴えは「疲労,たちくらみ,頭痛,記録が伸びない,後半走れない,熱中症を繰り返す,吐き気等」などでした。11例のクラブ活動種類は陸上部6人,バスケットボール部2人,野球部2人,ソフトテニス部1人と様々です。
検査結果:表1に示しますように,それぞれの中央値の値からは貧血との診断はできません。
このように,疲れやすいというあいまいな訴えの中に「行軍血色素尿症」は潜んでいるため,臨床症状だけで貧血を認めずとも,背景にオーバートレーニングなどがある時には「血清ハプトグロビン」の検査が有用です。
<鹿児島国体もあります>
2018年はスポーツ関係者にとって,2020年東京オリンピックに向けて,同時に鹿児島国体へ向けて準備の年になるでしょう。スポーツが国民を元気にするでしょうし,国体も鹿児島県民の意欲向上に役立つことは間違いありません。「アスリート健診」などで選手の体調管理ができ,潜在性の鉄欠乏状態やかくれた「行軍血色素尿症」などが明らかになるだけで,アスリートの体調管理はやりやすくなります。行軍血色素尿症そのものは,病気というよりもオーバートレーニングを避けるだけで克服可能です。公認スポーツ栄養士である「KAGO食スポーツのスタッフ」とも協力してアスリートにとって良い準備ができ,良い結果を残せるように,医療面からも協力していける1年にしたいと考えています。

|
このサイトの文章、画像などを許可なく保存、転載する事を禁止します。
(C)Kagoshima City Medical Association 2018 |